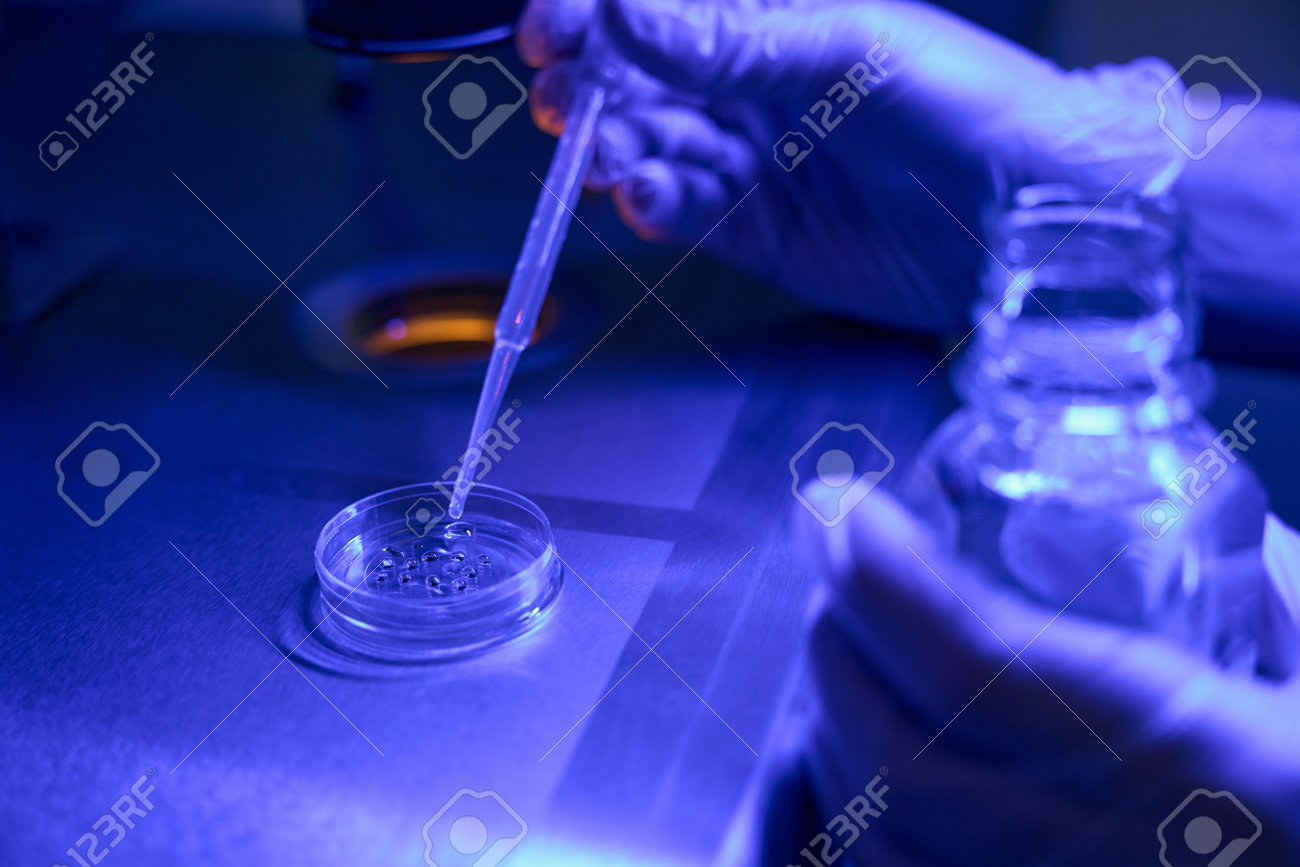
etiam-dictum-ipsum-a-felis

Download
Close
Автор:
id:
Ключевые слова:
advancement, analyzing, biochemistry, biologist, biology, biopsy, biotechnology, cell, closeup, collection, cultivation, cytoplasmic, development, embryo, embryologist, embryology, embryonic, equipment, examination, fertility, fertilization, flask, focus, genetic, glassware, growth, healthcare, icsi, idea, indoors, injection, innovation, intra, invitro, ivf, lab, laboratory, medicine, microscope, reproduction, research, science, sperm, stem, structure, technician, transfer, treatment, worker, working,





